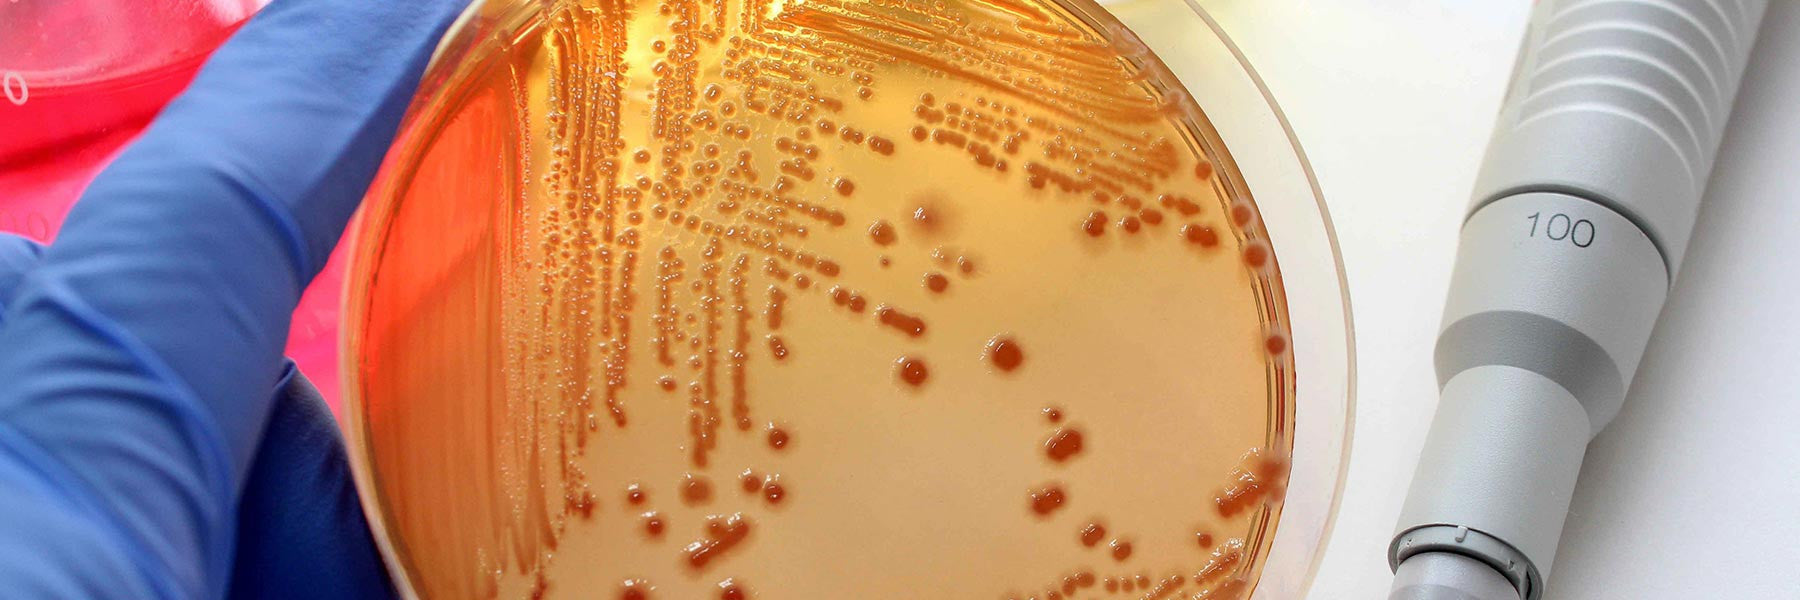
Microbiological Monitoring

PMT(GB) LTD
Microbiological Monitoring
Microbiological Monitoring
PMT (GB) Limited are able to offer Microbial Monitoring Air Samplers and Controller Systems manufactured by EMTEK.
EMTEK’s Microbial Air Samplers and Controller Systems provide Real-Time Microbial Monitoring and Bacteria Detection in clean room environments for a wide range of industries. Since 2009, EMTEK has been providing high-quality test equipment for environmental monitoring and microbiology. EMTEK is dedicated to supplying quality Microbial Monitoring and Air Viable Monitoring equipment that is reflective of both customer and industry needs.
To find out more about our products or request a meeting with your local specialist representative, get in touch today.
EMTEK’s Microbial Air Samplers and Controller Systems provide Real-Time Microbial Monitoring and Bacteria Detection in clean room environments for a wide range of industries. Since 2009, EMTEK has been providing high-quality test equipment for environmental monitoring and microbiology. EMTEK is dedicated to supplying quality Microbial Monitoring and Air Viable Monitoring equipment that is reflective of both customer and industry needs.
To find out more about our products or request a meeting with your local specialist representative, get in touch today.